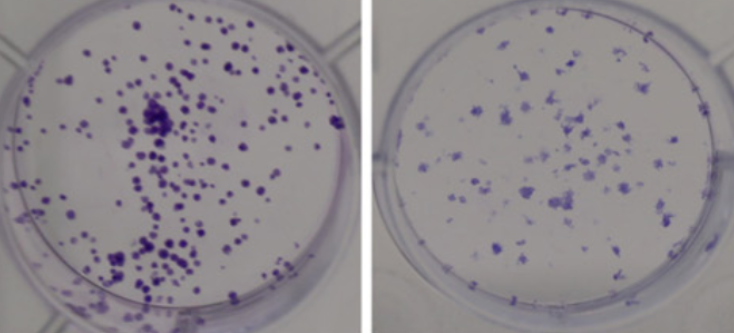

Hsa_circ_0023179 modulated the processes of proliferation, apoptosis, and EMT in non-small cell lung cancer cells via the miR-615-5p/CDH3 axis
DOI:
https://doi.org/10.17305/bb.2024.10944Keywords:
Non-small cell lung cancer, circ_0023179, Cadherin 3Abstract
Circular RNA (circRNA) has been widely studied as a competitive endogenous RNA targeting microRNA (miRNA)/messenger RNA to regulate cancer progression. However, the regulatory mechanism of circ_0023179 in non-small cell lung cancer (NSCLC) remains unclear. The expression levels of circ_0023179, miR-615-5p and Cadherin 3 (CDH3) in NSCLC were detected using quantitative real-time polymerase chain reaction. The stability of circ_0023179 was verified using ribonuclease R enzyme, actinomycin D and agarose gel electrophoresis. Colony formation and thymidine analog 5-ethynyl-2’-deoxyuridine assays were performed to examine proliferation changes in NSCLC cells. Western blot was used to assess the levels of CDH3 and epithelial-mesenchymal transition (EMT)–related marker proteins to evaluate EMT. Dual-luciferase reporter, RNA immunoprecipitation (RIP), and RNA pull-down assays were performed to explore the potential mechanisms of circ_0023179 in regulating NSCLC progression. Finally, the effects of circ_0023179 on NSCLC tumour growth in vivo were explored using a nude mouse subcutaneous tumour model. The results showed that the expression of circ_0023179 was remarkably higher in NSCLC tissues and cells, and it had a significant effect on NSCLC cell proliferation. Additionally, the knockdown of circ_0023179 significantly inhibited tumour growth in NSCLC mice. Mechanistically, circ_0023179 alleviated its inhibition of downstream CDH3 through the sponge-like adsorption of miR-615-5p. The downregulation of miR-615-5p and the upregulation of CDH3 mitigated the inhibitory effect of silencing circ_0023179 on NSCLC cell proliferation. In conclusion, silencing circ_0023179 inhibited NSCLC cell proliferation by targeting the miR-615-5p/CDH3 axis involved in NSCLC progression.
Citations
Downloads
Downloads
Published
Issue
Section
Categories
License
Copyright (c) 2024 Qingkui Guo, Min Zheng, Chen Zhu, Bin Wu

This work is licensed under a Creative Commons Attribution 4.0 International License.









